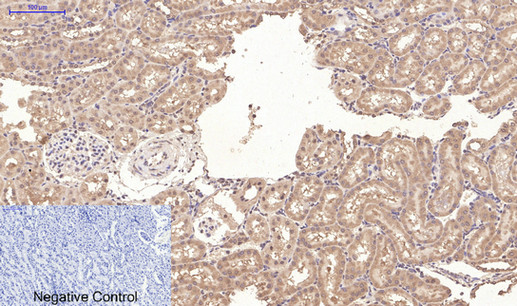

Mouse Monoclonal Antibody to CD10
货号:
P20386
别名:
MME; EPN; Neprilysin; Atriopeptidase; Common acute lymphocytic leukemia antigen; CALLA; Enkephalinase; Neutral endopeptidase 24.11; NEP; Neutral endopeptidase; Skin fibroblast elastase; SFE; CD10
应用:
IHC
反应种属:
Human,Mouse,Rat
抗体类型:
Primary antibody
Swissprot:
P08473
规格:
目录价
在线咨询
Description |
|---|
CD10 is a transmembrane type II molecule and functions as a metallo-peptidase requiring zinc. Specifically, CD10 cleaves 1-3 amino-terminal amino acids from peptides with a preference for neutral amino acids (valine, iso-leucine, phenylalanine, leucine or alanine). Involved in the degradation of atrial natriuretic factor (ANF). Displays UV-inducible elastase activity toward skin preelastic and elastic fibers. |
Specification |
|
|---|---|
| Aliases | MME; EPN; Neprilysin; Atriopeptidase; Common acute lymphocytic leukemia antigen; CALLA; Enkephalinase; Neutral endopeptidase 24.11; NEP; Neutral endopeptidase; Skin fibroblast elastase; SFE; CD10 |
| Entrez GeneID | 4311 |
| Swissprot | P08473 |
| clone | 6F7 |
| Host/Isotype | Mouse IgG1 |
| Antibody Type | Primary antibody |
| Storage | Store at 4°C short term. Aliquot and store at -20°C long term. Avoid freeze/thaw cycles. |
| Species Reactivity | Human,Mouse,Rat |
| Immunogen | Synthetic peptide conjugated to KLH. |
| Formulation | Purified antibody in PBS with 0.05% sodium azide,0.5%BSA and 50% glycerol. |
Application |
|
|---|---|
| IHC | 1/50-1/100 |
Product Image
-
Immunofluorescence analysis of CD10 in Human uterus tissue using CD10 antibody(red),and DAPI (blue).

-
Immunofluorescence analysis of CD10 in rat kidney using CD10 antibody(red),and DAPI (blue).

-
Immunohistochemistry analysis of paraffin-embedded Human uterus tissue using CD10 antibody. High-pressure and temperature Sodium Citrate pH 6.0 was used for antigen retrieval. Negative control was used by secondary antibody only.

-
Immunohistochemistry analysis of paraffin-embedded mouse lung tissue using CD10 antibody.High-pressure and temperature Sodium Citrate pH 6.0 was used for antigen retrieval.Negative control was used by secondary antibody only.

-
Immunohistochemistry analysis of paraffin-embedded Human breast cancer using CD10 antibody.High-pressure and temperature Sodium Citrate pH 6.0 was used for antigen retrieval.v

-
Immunohistochemistry analysis of paraffin-embedded rat kidney tissue using CD10 antibody.High-pressure and temperature Sodium Citrate pH 6.0 was used for antigen retrieval. Negative control was used by secondary antibody only.

鄂公网安备42018502007531号
鄂公网安备42018502007531号

